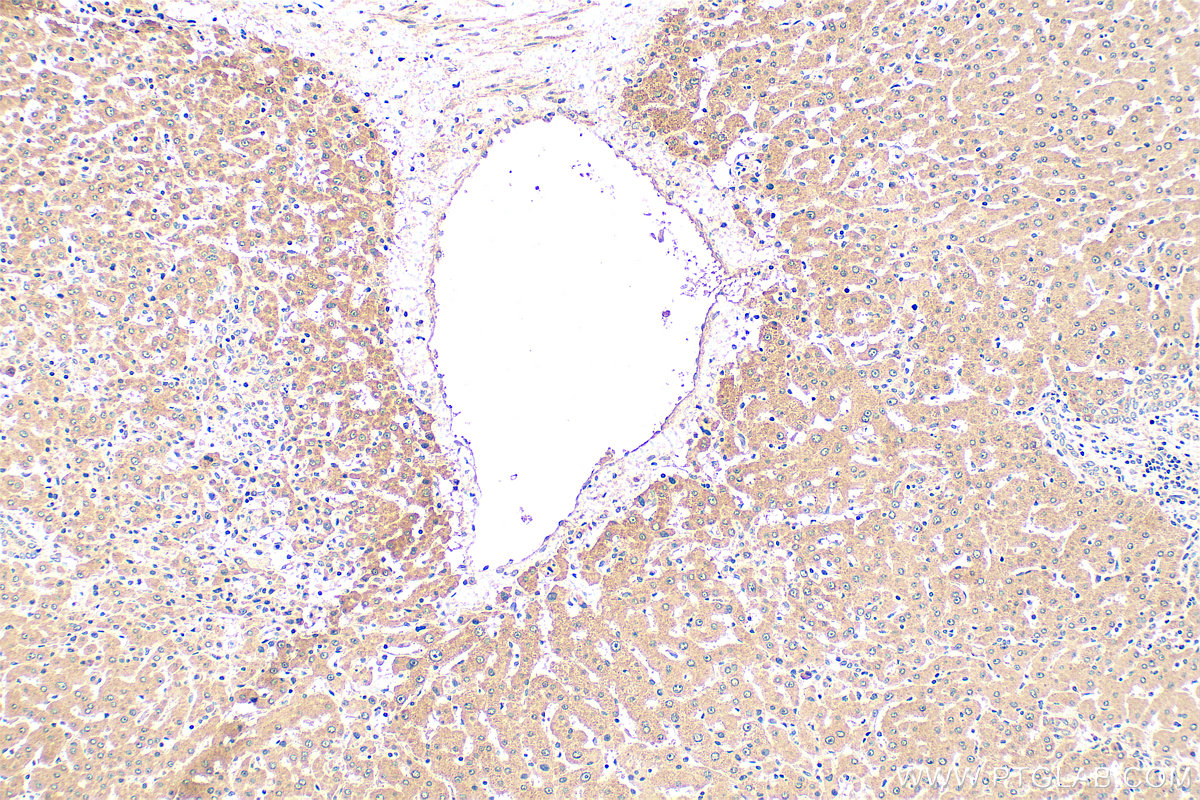
IHC staining of human hepatocirrhosis using 24069-1-AP
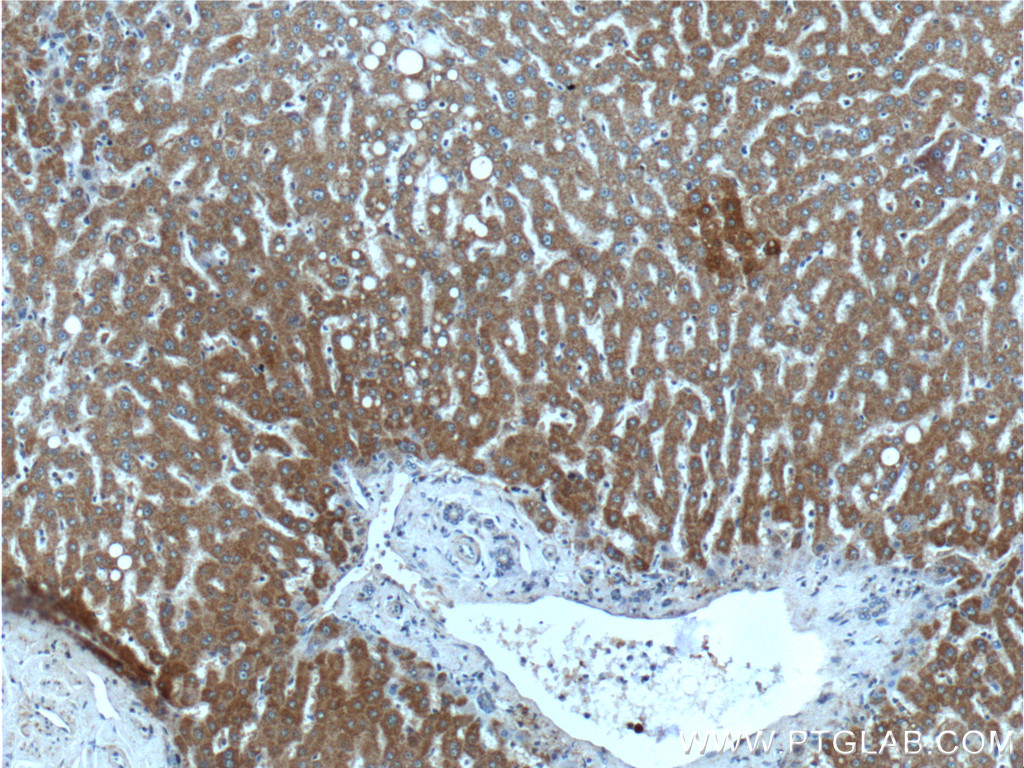

验证数据展示
经过测试的应用
| Positive WB detected in | human plasma, mouse lung tissue, mouse serum, rat serum |
| Positive IHC detected in | human hepatocirrhosis tissue, human liver tissue Note: suggested antigen retrieval with TE buffer pH 9.0; (*) Alternatively, antigen retrieval may be performed with citrate buffer pH 6.0 |
推荐稀释比
| 应用 | 推荐稀释比 |
|---|---|
| Western Blot (WB) | WB : 1:500-1:2000 |
| Immunohistochemistry (IHC) | IHC : 1:50-1:500 |
| It is recommended that this reagent should be titrated in each testing system to obtain optimal results. | |
| Sample-dependent, Check data in validation data gallery. | |
产品信息
24069-1-AP targets ITIH4 in WB, IHC, IF, IP, ELISA applications and shows reactivity with human, mouse, rat samples.
| 经测试应用 | WB, IHC, ELISA Application Description |
| 文献引用应用 | WB, IHC, IF, IP |
| 经测试反应性 | human, mouse, rat |
| 文献引用反应性 | human, mouse |
| 免疫原 |
CatNo: Ag21275 Product name: Recombinant human ITIH4 protein Source: e coli.-derived, PGEX-4T Tag: GST Domain: 622-932 aa of BC136393 Sequence: STFFKYYLQGAKIPKPEASFSPRRGWNRQAGAAGSRMNFRPGVLSSRQLGLPGPPDVPDHAAYHPFRRLAILPASATPATSNPDPAVSRVMNMKIEETTMTTQTPAPIQAPSAILPLPGQSVERLCVDPRHRQGPVNLLSDPEQGVEVTGQYEREKAGFSWIEVTFKNPLVWVHASPEHVVVTRNRRSSAYKWKETLFSVMPGLKMTMDKTGLLLLSDPDKVTIGLLFWDGRGEGLRLLLRDTDRFSSHVGGTLGQFYQEVLWGSPAASDDGRRTLRVQGNDHSATRERRLDYQEGPPGVEISCWSVEL 种属同源性预测 |
| 宿主/亚型 | Rabbit / IgG |
| 抗体类别 | Polyclonal |
| 产品类型 | Antibody |
| 全称 | inter-alpha (globulin) inhibitor H4 (plasma Kallikrein-sensitive glycoprotein) |
| 别名 | 35 kDa inter-alpha-trypsin inhibitor heavy chain H4, 70 kDa inter-alpha-trypsin inhibitor heavy chain H4, IHRP, Inter-alpha-inhibitor heavy chain 4, Inter-alpha-trypsin inhibitor family heavy chain-related protein |
| 计算分子量 | 103 kDa |
| 观测分子量 | 120 kDa |
| GenBank蛋白编号 | BC136393 |
| 基因名称 | ITIH4 |
| Gene ID (NCBI) | 3700 |
| RRID | AB_2879426 |
| 偶联类型 | Unconjugated |
| 形式 | Liquid |
| 纯化方式 | Antigen Affinity purified |
| UNIPROT ID | Q14624 |
| 储存缓冲液 | PBS with 0.02% sodium azide and 50% glycerol, pH 7.3. |
| 储存条件 | Store at -20°C. Stable for one year after shipment. Aliquoting is unnecessary for -20oC storage. |
背景介绍
ITIH4(Inter-alpha-trypsin inhibitor heavy chain H4) is a liver-restricted plasma glycoprotein belonging to the serine protease inhibitor family, playing diverse roles in inflammation, extracellular matrix (ECM) stabilization, and cancer progression. Expressed mainly in hepatocytes, ITIH4 is secreted into the bloodstream, where it can be cleaved by plasma kallikrein into specific fragments. Functionally, ITIH4 acts as an anti-apoptotic and matrix-stabilizing molecule during liver development and regeneration, with its expression regulated by interleukin-6 (IL-6).
实验方案
| Product Specific Protocols | |
|---|---|
| IHC protocol for ITIH4 antibody 24069-1-AP | Download protocol |
| WB protocol for ITIH4 antibody 24069-1-AP | Download protocol |
| Standard Protocols | |
|---|---|
| Click here to view our Standard Protocols |
发表文章
| Species | Application | Title |
|---|---|---|
Cardiovasc Res Translatome profiling reveals Itih4 as a novel smooth muscle cell-specific gene in atherosclerosis | ||
Matrix Biol Proteome-wide and matrisome-specific atlas of the human ovary computes fertility biomarker candidates and open the way for precision oncofertility. | ||
Front Oncol Mining of RNA Methylation-Related Genes and Elucidation of Their Molecular Biology in Gallbladder Carcinoma. | ||
Clin Exp Immunol Citrullinated inter-alpha-trypsin inhibitor heavy chain 4 in arthritic joints and its potential effect in the neutrophil migration. | ||
BMC Cancer Elevated levels of circulating ITIH4 are associated with hepatocellular carcinoma with nonalcoholic fatty liver disease: from pig model to human study. | ||
Dis Markers Plasma Inter-Alpha-Trypsin Inhibitor Heavy Chains H3 and H4 Serve as Novel Diagnostic Biomarkers in Human Colorectal Cancer. |